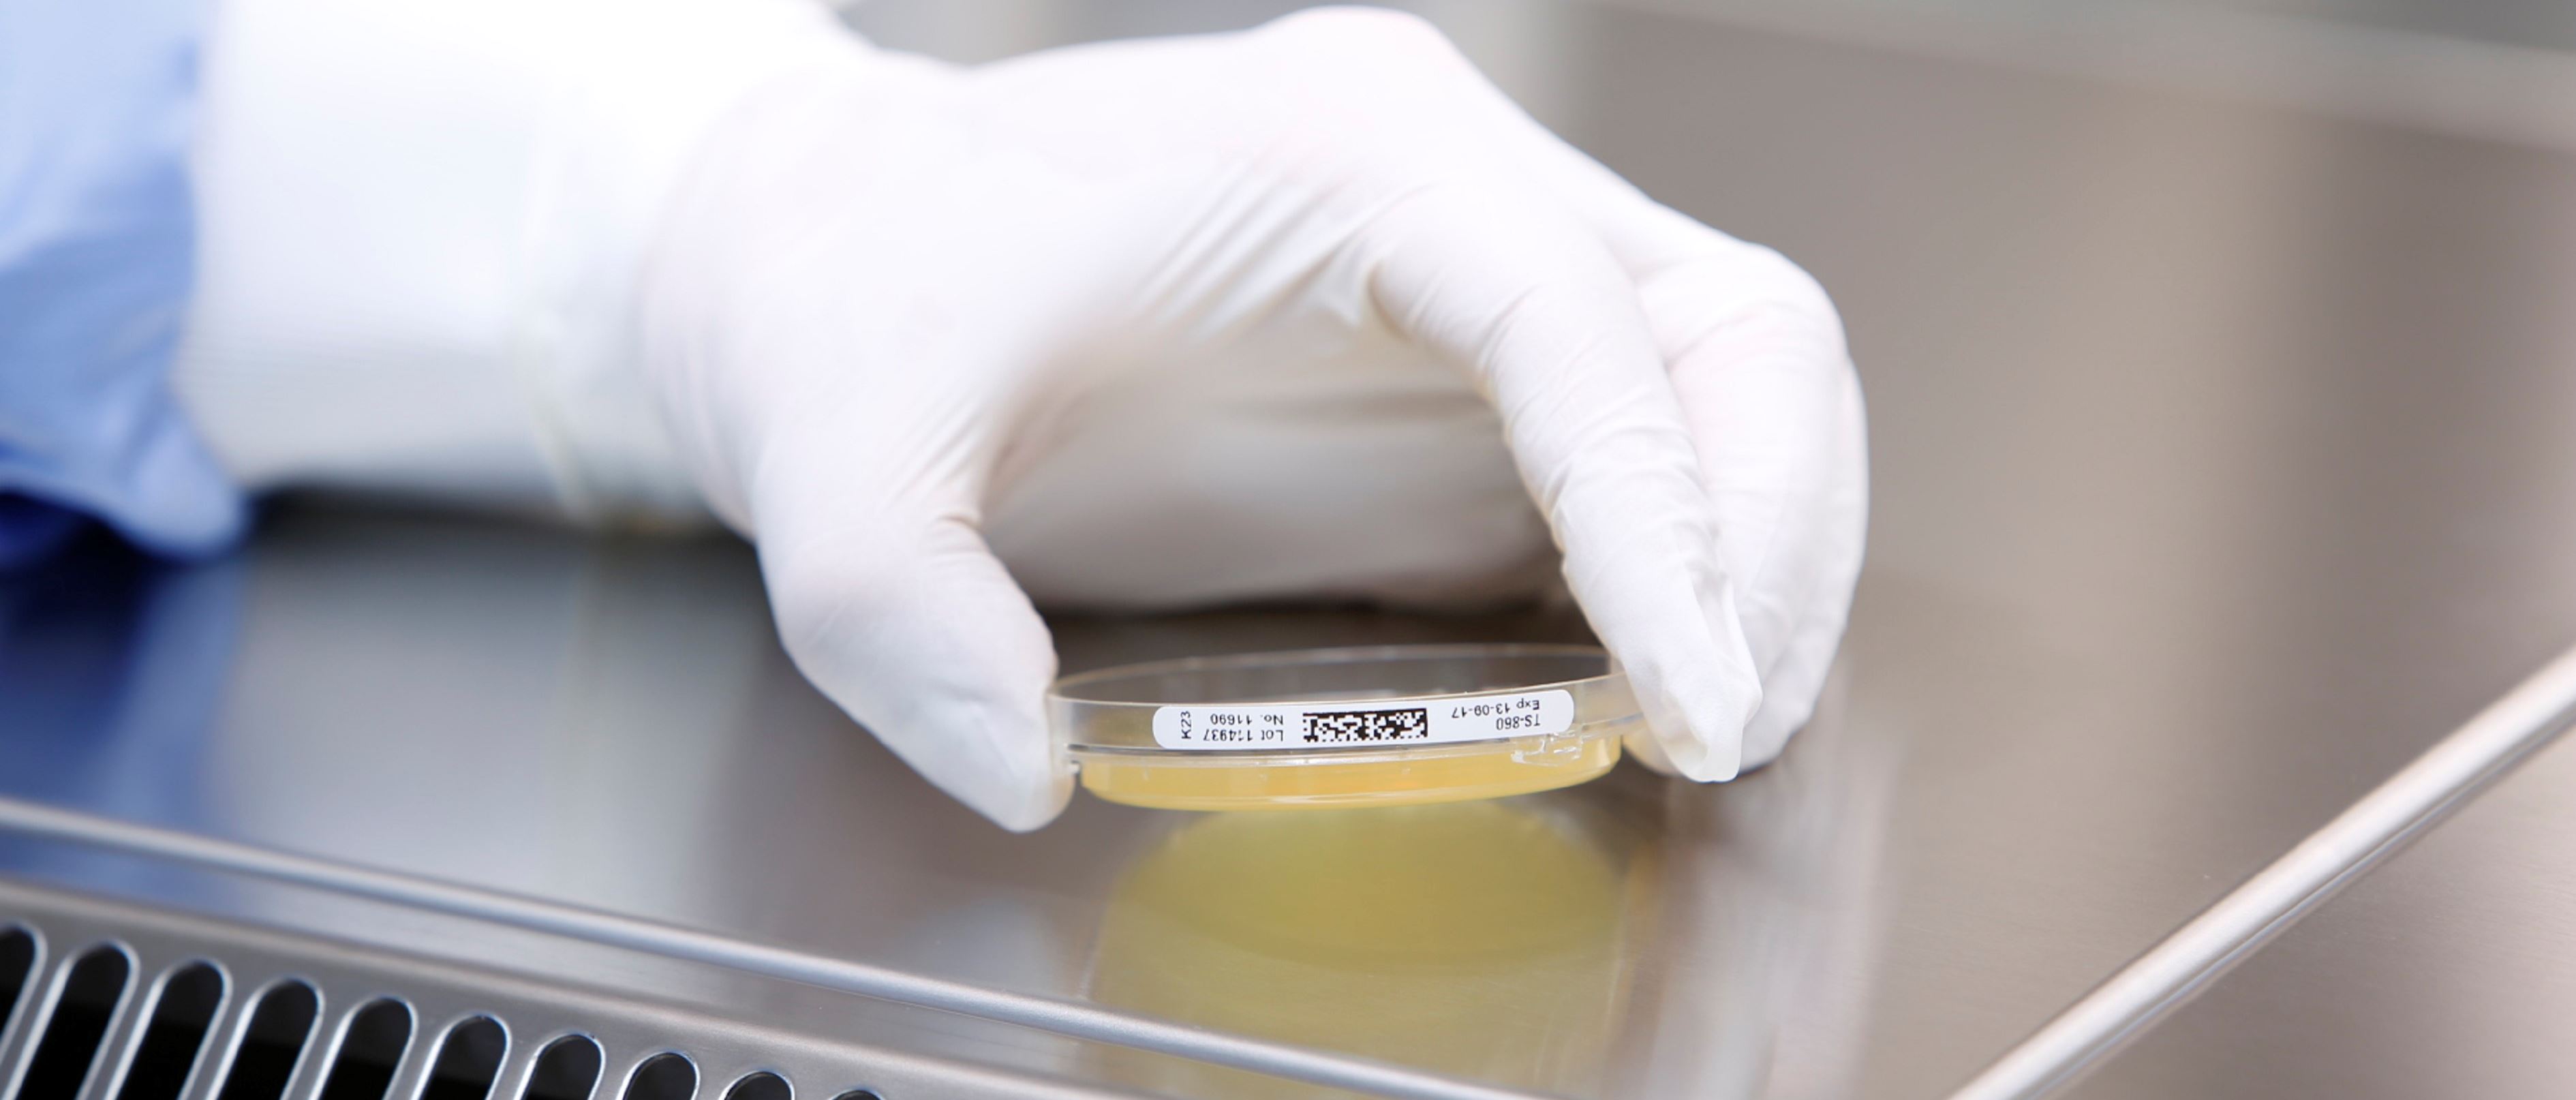
Ausbildung Reinraum-Reinigung.jpg Ausbildung Reinraum-Reinigung.jpg

Eine solide GMP-Grundausbildung und regelmässige Schulungen sind Voraussetzungen für Reinigungsmitarbeitende, um die in Reinräumen geltenden hohen hygienischen und regulatorischen Vorgaben einhalten zu können.



Eine solide GMP-Grundausbildung und regelmässige Schulungen sind Voraussetzungen für Reinigungsmitarbeitende, um die in Reinräumen geltenden hohen hygienischen und regulatorischen Vorgaben einhalten zu können.
Grundkurs Reinraum-Reinigung
Unverzichtbare Voraussetzung für alle weiterführenden Reinraum-Ausbildungen ist der Grundkurs Reinraum-Reinigung. Dieser umfasst persönliche SicherheitsundSchutzausrüstungen, Reinigungstechniken sowie die korrekte Anwendung geeigneter Reinigungsgeräte und -materialien. Zudem vermitteln wir von der Enzler Hygiene AG den Mitarbeitenden Kenntnisse über Desinfektionsmittel, das strikte Vorgehen nach SOP und die erforderliche Dokumentation aller Arbeitsschritte.
GMP-Grundkurs
Die gute Herstellungspraxis (GMP) mit ihren regulatorischen Anforderungen sowie der Anpassung an internationale Standards erfordert eine fortlaufende Überprüfung und Aktualisierung aller z.B. mit der Arzneimittelproduktion verbundenen Prozesse. Im GMP-Grundkurs machen wir unser Fachpersonal vertraut mit regulatorischen und gesetzlichen Auflagen und sensibilisieren das Qualitätsbewusstsein und die damit verbundene Verantwortung. Die Reinigungsmitarbeitenden erlernen das Identifizieren von Fehlerquellen, um korrektive und präventive Massnahmen ergreifen zu können. Komplettiert wird das GMP-Grundmodul durch Workshops zu den Themen Dokumentationspraxis, Qualitätssicherungssysteme, Validierung und Qualifizierung.
Reinigung GMP-Klasse C–D
In den Kursen, die den GMP-Klassen entsprechend eingestuft sind, geht es um die Schulung der für die einzelnen Klassen erforderlichen Wissensbereiche rund um die Reinigung. Die GMP-Klassen C–D umfassen Bereiche, in denen nicht steril gearbeitet wird und solche mit weniger strengen Anforderungen als bei der Sterilproduktion. Die Mitarbeitenden vertiefen ihr Wissen zur Bedeutung der in diesen Bereichen hergestellten Produkte und den entsprechenden Verhaltens- und Sicherheitsregeln und lernen die Ankleideprozeduren kennen. Zudem werden Kenntnisse über zu verwendende Reinigungsgeräte und -hilfsmittel sowie über Desinfektionsmittel erworben.
Reinigung GMP-Klasse A–B
Die Anforderungen in Reinräumen der GMP-Klassen A und B sind wesentlich höher, da hier steril produziert wird. Dementsprechend werden den Teilnehmenden die wichtigsten Kompetenzen für diese sterilen Produktionsbereiche durch unsere Schulungsverantwortliche vermittelt. Besondere Relevanz haben hierbei das Verhalten der Mitarbeitenden und die korrekte Bekleidung.
Zielgruppen
• Mitarbeitende aus GMP- oder FDA-relevanten Arbeitsbereichen
• Reinraum-Verantwortliche mit Bedarf an regelmässigen Aus- und Weiterbildungen